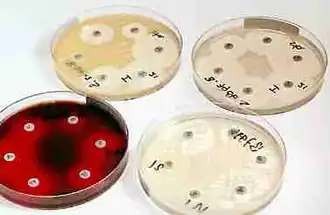

Voedingsbodem

Een voedingsbodem of groeimedium is een substraat met voedingsstoffen, bedoeld om schimmels, bacteriën of planten te kweken, meestal voor onderzoek. Zoals de naam aangeeft, levert deze ondergrond de voedingsstoffen voor de organismen die erin/-op leven; eventuele larven kunnen zich erin nestelen.
Voedingsbodem bij plantaardige weefselkweek
Bij plantaardige weefselkweek bestaat een voedingsbodem meestal uit de volgende onderdelen:
- Water: hierin worden alle andere stoffen opgelost
- Voedingszouten: dit zijn stoffen zoals stikstof (als nitraat), fosfor (als fosfaat) en metalen zoals natrium, calcium, kalium, ijzer; kortom allemaal mineralen.
- Een koolstofbron: meestal gewone suiker (sacharose). Normaal heeft een plant geen suiker nodig. Planten kunnen namelijk zelf energie vastleggen door fotosynthese. Echter in de plantaardige weefselkweek zijn vaak minder bladeren aanwezig. Ook is het kunstlicht in een klimaatcel vaak onvoldoende om zelf energie te kunnen vastleggen.
- Vitaminen
- Groeistoffen of plantenhormonen: door deze stoffen toe te voegen wordt bereikt dat de planten meerdere groeipunten vormen. Daardoor verkrijgt men sneller en meer planten dan zonder deze stoffen.
- Bindmiddel: agaragar. Dit wordt toegevoegd om de voedingsbodem stevig te maken.
Als alle stoffen zijn opgelost, wordt de vloeistof in buisjes of kuipjes gegoten. Daarna wordt het in een autoclaaf verhit tot circa 121°C om ervoor te zorgen dat alle bacteriën en schimmels worden gedood. Het is immers de bedoeling dat de planten onder steriele omstandigheden worden gekweekt.
Voedingsbodem voor micro-organismen

Voor het onderzoek van micro-organismen, zoals schimmels en bacteriën, wordt in een petrischaal een voedingsmedium gegoten dat bestaat uit agar-agar met daarin opgeloste voedingsstoffen. Het petrischaaltje en het voedingsmedium zijn op voorhand gesteriliseerd. Sommige voedingsmedia zijn selectief voor specifieke organismen; andere organismen kunnen in dergelijke bodems niet uitgroeien.
Enkele veelgebruikte voedingsbodems: